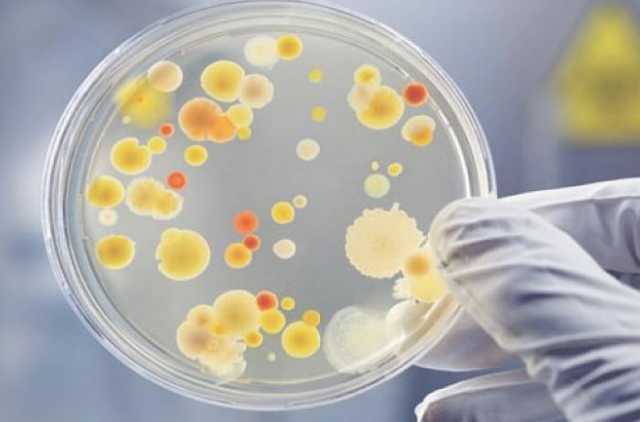
В Украине бушует ботулизм

В Украине бушует ботулизм
В Украине бушует ботулизм
Об этом сообщает Центр общественного здоровья.
"С начала года и по состоянию на 15 июля в Украине зафиксировано 40 случаев ботулизма, из них двое детей 9 и 13 лет. Два человека умерли", - говорится в сообщении.
Центр общественного здоровья предупреждает, что употребление изготовленных в домашних условиях консервов, вяленой, копченой, соленой рыбы и других продуктов питания, приобретенных в местах несанкционированной торговли, может привести к заболеванию ботулизмом.
Ботулизм — это тяжелое пищевое отравление, вызванное потреблением продуктов, содержащих ботулотоксины.
Лучший способ защитить свое здоровье — воздерживаться от приема пищи, о качестве которой потребителю неизвестно.
Центр общественного здоровья Украины призывает украинцев ответственно относиться к своему здоровью и не употреблять вяленую, соленую и консервированную рыбу, консервы или изделия из мяса без надлежащей термообработки.
Теги: БолезнисмертьУкраинаБотулизм
Коментарі:
comments powered by DisqusЗагрузка...
Наші опитування
Показати результати опитування
Показати всі опитування на сайті
